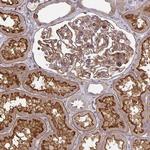
Tensin 3 Antibody in Immunohistochemistry (IHC)

Search
Invitrogen
Tensin 3 Polyclonal Antibody
{{$productOrderCtrl.translations['antibody.pdp.commerceCard.promotion.promotions']}}
{{$productOrderCtrl.translations['antibody.pdp.commerceCard.promotion.viewpromo']}}
{{$productOrderCtrl.translations['antibody.pdp.commerceCard.promotion.promocode']}}: {{promo.promoCode}} {{promo.promoTitle}} {{promo.promoDescription}}. {{$productOrderCtrl.translations['antibody.pdp.commerceCard.promotion.learnmore']}}

Please note: We are reviewing Western blot images included in the antibody testing data in our catalog, including those provided by third parties. Unless expressly labeled or annotated as “raw-unedited”, Western blot images included in the antibody testing data in our catalog may have been edited, optimized or otherwise adjusted for presentation.
产品信息
PA5-63238
种属反应
宿主/亚型
分类
类型
抗原
偶联物
形式
浓度
规格
纯化类型
保存液
内含物
保存条件
运输条件
RRID
产品详细信息
Immunogen sequence: VGSGPHPPDT QQPSPSKAFK PRFPGDQVVN GAGPELSTGP SPGSPTLDID QSIEQLNRLI LELDPTFEPI PTHMNALGSQ ANGSV
Highest antigen sequence identity to the following orthologs: Mouse - 69%, Rat - 73%.
靶标信息
The Tensin (Tns) family of proteins is involved in the maintenance of cellular structure by anchoring actin filaments at the focal adhesion via F-actin binding and capping activities. Tns proteins also contain a Src homology 2 (SH2) domain and have the ability to be phosphorylated, suggesting a role in signal transduction cascades. These diverse characteristics indicate that Tns proteins may be important links between the cytoskeleton and signal transduction pathways. Tns3, also known as TEM6 or TENS1, localizes to the focal adhesions of the plasma membrane. It is predominantly expressed in thyroid and placenta but can also be found in heart, liver, brain, prostate, pancreas, kidney, lung, skeletal muscle and white blood cells. Tns3 is essential for proper growth and development, as suggested by growth retardation and death in a number of Tns3-/- mice.
仅用于科研。不用于诊断过程。未经明确授权不得转售。
篇参考文献 (0)
生物信息学
蛋白别名: TENS3; Tensin-3; Tensin-like SH2 domain-containing protein 1; Tumor endothelial marker 6
基因别名: TEM6; TENS1; TNS3; TPP
Entrez Gene ID: (Human) 64759




